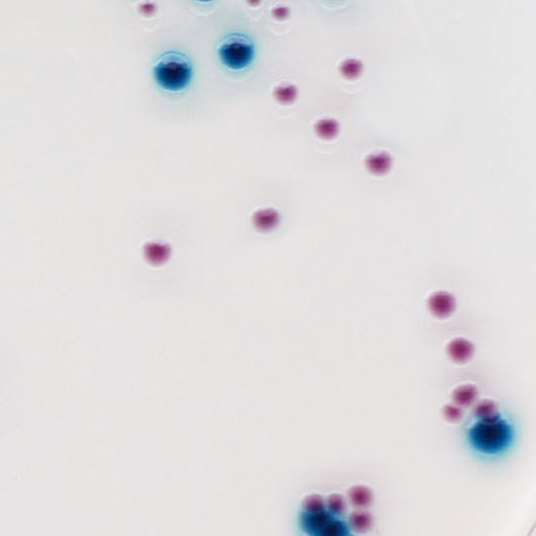
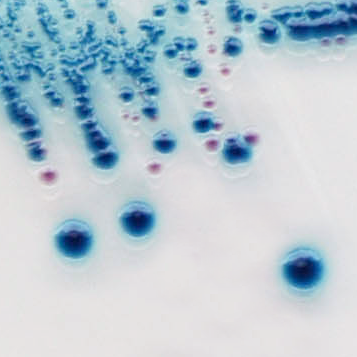

CHROMagar™ STEC
Để phát hiện E. coli sản sinh độc tố Shiga (STEC).
Thông tin đặt hàng
– ST162…….5000ml
Bao gồm: Base ST162(B) + supplement ST162(S)
– ST163-10kg…….Bao 10kg
Bao gồm: Base ST163-10kg(B) + supplement ST163-325(S)
KHUẨN LẠC ĐIỂN HÌNH
Độc tố Shiga E. coli typ huyết thanh phổ biến
Màu tím hoa cà
Enterobacteriaceae khác
Không màu, màu xanh hoặc bị ức chế
Hiệu NĂNG
Gần đây, ngày càng có nhiều nghiên cứu cho thấy rằng vi khuẩn E. coli (STEC) không sinh ShigaToxin (STEC) không phải O157 là nguyên nhân gây ra các đợt bùng phát ngộ độc thực phẩm. CDC cũng đã báo cáo cảnh báo về nguy cơ tiềm ẩn này:
“Bệnh do vi khuẩn Escherichia coli (STEC) sản sinh độc tố Shiga bao gồm tiêu chảy tự khỏi đến viêm đại tràng xuất huyết và hội chứng tan máu tăng urê huyết (HUS). Serotype O157:H7, loại STEC thường gặp nhất gây viêm đại tràng xuất huyết và HUS, đã được phân lập từ các đợt dịch lớn do thực phẩm cũng như các trường hợp nhỏ lẻ ở Bắc Mỹ và nước ngoài. Tuy nhiên, 60 loại huyết thanh STEC có liên quan đến bệnh tiêu chảy và một số loại huyết thanh không phải O157:H7 được cho là nguyên nhân gây ra các vụ dịch do thực phẩm và HUS ở Hoa Kỳ, Châu Âu và Úc. Các nghiên cứu từ Canada, Châu Âu, Argentina và Úc cho thấy rằng nhiễm trùng không phải O157:H7 STEC phổ biến hoặc cao hơn nhiễm trùng O157:H7.”
Báo cáo của CDC « Tỷ lệ nhiễm Escherichia coli sản sinh độc tố Shiga không phải O157:H7 trong các mẫu phân tiêu chảy […]»
Do đó, một số cơ quan quản lý kêu gọi ngành công nghiệp thực phẩm trên toàn thế giới thực hiện các biện pháp để kiểm soát sự vắng mặt của các sinh vật này trong quá trình sản xuất. Trong nhiều trường hợp, các phòng thí nghiệm đã giới hạn việc tìm kiếm vi khuẩn E. coli gây bệnh ở loại huyết thanh O157 thông thường. Điều này là do, thực tế là không có sẵn môi trường nuôi cấy chọn lọc đối với vi khuẩn E. coli không phải O157 .
CHROMagar™ STEC được sản xuất để: phát hiện, dưới dạng khuẩn lạc màu hoa cà, không chỉ của STEC O157 truyền thống mà còn của nhiều loại huyết thanh khác.
Mục đích sử dụng
CHROMagar™ STEC là môi trường nuôi cấy sinh màu chọn lọc nhằm mục đích sử dụng để phát hiện định tính trực tiếp, phân biệt và nhận dạng giả định của Escherichia coli (STEC) sản sinh độc tố giống Shiga, để hỗ trợ chẩn đoán nhiễm trùng STEC. Xét nghiệm được thực hiện bằng mẫu tăm bông trực tràng và phân. Kết quả có thể được giải thích sau 18-24 giờ ủ hiếu khí ở 35-37°C.
Nuôi cấy đồng loạt là cần thiết để phục hồi các sinh vật để thử nghiệm vi sinh hoặc phân loại dịch tễ học thêm. Việc thiếu sự phát triển hoặc không có khuẩn lạc màu tím hoa cà trên CHROMagar™ STEC không loại trừ sự hiện diện của STEC. CHROMagar™ STEC không nhằm mục đích chẩn đoán nhiễm trùng cũng như không hướng dẫn hay theo dõi việc điều trị nhiễm trùng.
CHROMagar™ STEC cũng có thể được sử dụng để phát hiện STEC trong phân tích các sản phẩm thực phẩm dành cho con người, thức ăn chăn nuôi và trong các mẫu môi trường.
1. Dễ đọc kết quả: Phần lớn các chủng STEC phát triển có màu hoa cà, trong khi các vi khuẩn khác phát triển có màu xanh lam, không màu hoặc bị ức chế.
2. Môi trường chọn lọc STEC cao: Công cụ tuyệt vời cho số lượng lớn quy trình sàng lọc mẫu.

3. Lần đầu tiên trên toàn thế giới: Môi trường duy nhất trên thị trường để phát hiện STEC.
4. Tính linh hoạt : Nó có thể được bổ sung các hợp chất bổ sung để khiến nó có tính chọn lọc cao hơn đối với chủng gây bùng phát.
Thành phần

tài liệu kỹ thuật
công bố khoa học
2022
Độc tố Shiga không O157 sản sinh Escherichia coli (STEC) ở Alberta, Canada từ năm 2018-2021
2020
Đánh giá thạch chọn lọc sinh màu (CHROMagar STEC) để phát hiện trực tiếp Escherichi coli sinh độc tố Shiga từ mẫu phân
2018
Đặc điểm của STEC và E. coli gây tiêu chảy khác được phân lập trên CHROMagar™ STEC tại bệnh viện tuyến trên, Cape Town


